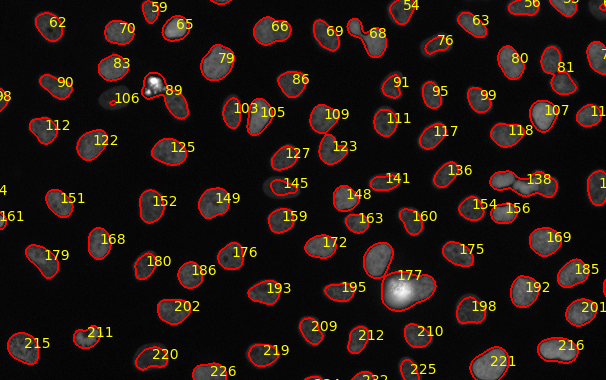

Biomedical Computer Vision (BMCV)
Prof. Dr. Karl Rohr
Software
Galaxy Image Analysis
Overview: https://www.bioquant.uni-heidelberg.de/groups/rohr/gia
GitHub: https://github.com/BMCV/galaxy-image-analysis

Galaxy Image Analysis: Capturing Mitoflashes
Workflow: https://usegalaxy.eu/u/bmcv/w/capturing-mitoflashes
Paper: https://doi.org/10.1097/j.pain.0000000000002642

Galaxy Image Analysis: MALDI and Histology Data

Galaxy Docker ParaView
GitHub: https://github.com/BMCV/docker-paraviewweb
Now maintained at: https://github.com/BMCV/docker-paraview

Galaxy Image Analysis Online Training
Course: https://www.denbi.de/online-training-media-library/744-image-analysis-using-galaxy-tools
ActiPHV: Tracking Analysis of Actin Filaments
GitHub: https://github.com/BMCV/ActiPHV

quantAFM: Quantification of Atomic Force Microscopy (AFM) Images
GitHub: https://github.com/BMCV/quantAFM
